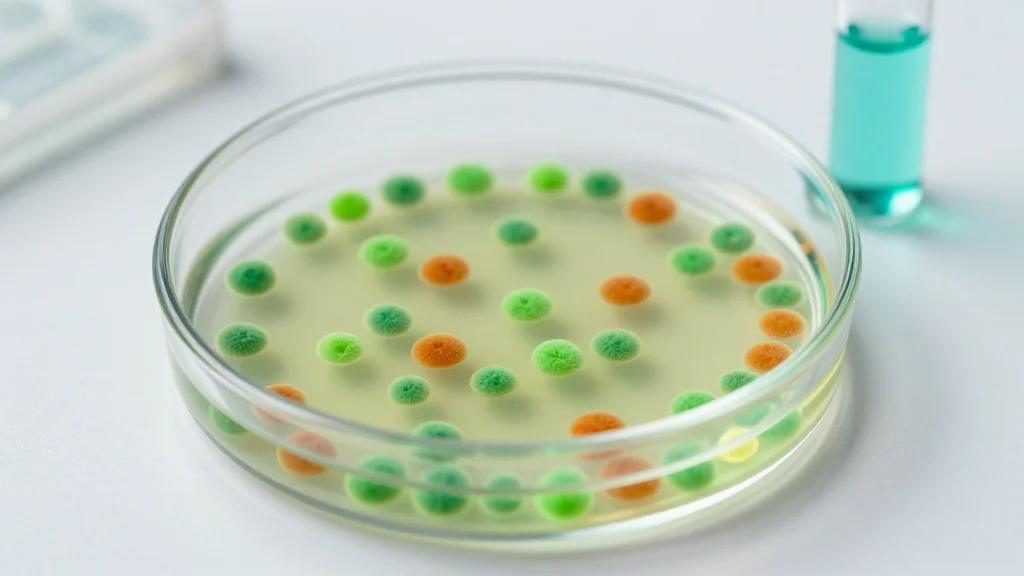
Programmable Targeted Hypermutagenesis via Diversity-Generating Retroelements

The Solar Support Gap: Why Do Pro-Solar Citizens Reject Local Projects?
University of Rhode Island researchers examined why voters who support solar energy opposed a utility‑scale solar project in North Kingstown, Rhode Island. An exit‑poll revealed that 28.9% of pro‑solar respondents voted against the 2019 referendum, creating an individual support gap. The study found land‑use concerns—especially deforestation—outweighed proximity worries, and that low trust in government and climate‑change denial amplified opposition. Researchers suggest building trust and avoiding forested sites to shrink the gap in future projects.

OpenAI Agents SDK Improves Governance with Sandbox Execution
OpenAI has launched sandbox execution within its Agents SDK, giving enterprises a model‑native harness that isolates code, credentials, and data. The new infrastructure lets developers run autonomous agents in controlled containers, connect to major cloud storage, and snapshot state for...

Virginia Governor Abigail Spanberger Signs Legislation Mandating 20.78GW of Energy Storage
Virginia Governor Abigail Spanberger signed HB 895 and SB 448, mandating 20.78 GW of energy‑storage capacity across the Commonwealth. Appalachian Power must deliver 780 MW of short‑duration and 520 MW of long‑duration storage by 2040‑2045, while Dominion Energy is tasked with 16 GW short‑duration and 3.48 GW...

Eurobites: Iliad's Digital Payments Unit Enters Italian Market
Iliad’s Stancer unit has launched in Italy, offering a home‑grown payments platform for small and midsized enterprises that supports both e‑commerce and tap‑to‑pay transactions. The service keeps all data in Iliad’s European data centres, guaranteeing GDPR compliance. At the same...

TCI Aircraft Interiors to Become New HBCplus Provider Following Collaboration with Airbus
Airbus and Turkish cabin specialist TCI Aircraft Interiors signed an MOU to add TCI as a Managed Service Provider for Airbus' HBCplus satellite connectivity platform. The agreement will initially deliver a proposal for Turkish Airlines' Airbus fleet, integrating TCI into...

How SaaS Companies Are Monetizing AI Agents in 2026
SaaS firms are increasingly monetizing AI agents to boost net revenue retention, with top‑quartile companies hitting roughly 130% NRR by embedding generative AI across product suites. AI‑driven contract management tools are slashing legal cycle times, while regulatory‑focused SaaS platforms are...

Colombia Approves Guidelines for Integrating Energy Storage Into Electricity System
Colombia issued Decree 0393 to establish public‑policy guidelines for integrating energy‑storage systems (ESS) into both the National Interconnected System and isolated zones. The decree sets deployment criteria, market participation rules, and a remuneration framework, recognizing storage for frequency regulation, voltage...

Oxylabs Research: ChatGPT Co-Authored 42 Academic Papers, Accumulated 1,952 Citations
Oxylabs Research used its AI Studio platform to examine Google Scholar data from 2022‑2025, finding that ChatGPT was listed as a co‑author on 42 scholarly papers across twelve fields and six languages. Those papers have accumulated 1,952 citations, giving the...

Health Tech Innovators and Industry Experts Invited to Join Fast-Paced Innovation Sprint to Accelerate Solutions
Health Tech Enterprise has opened applications for its Health Innovation Sprints, a one‑day intensive workshop series scheduled for 11 May 2026 in London and 2 June 2026 at the Imperial War Museum Duxford, Cambridge, with the latter focusing on paediatrics. The program invites NHS...

EdgeBeam Wireless and Soracom Partner to Extend Last-Mile Connectivity over Hybrid Cellular and Broadcast Networks
EdgeBeam Wireless announced a partnership with Soracom, making the Japanese IoT platform the first cellular partner on EdgeBeam’s hybrid network operator platform. The collaboration blends EdgeBeam’s ATSC 3.0 broadcast capability with Soracom’s 4G/5G connectivity, creating a dual‑path solution that can broadcast...

Phase III Study of Lilly’s Foundayo, Reaffirms Cardiovascular and Overall Safety Profile, Plus Improvements to Cardiometabolic Health
Eli Lilly announced that its oral GLP‑1 drug Foundayo (orforglipron) achieved the primary endpoint in the Phase 3 ACHIEVE‑4 trial, demonstrating non‑inferior major adverse cardiovascular event risk versus insulin glargine. The study, the largest of its kind with over 2,700 participants...

Balancing Water Savings with Real-World Performance
Modern restroom fixtures are engineered to slash water use through lower flow rates, pressure‑compensating spray outlets, and metered run times while preserving hand‑washing performance. Manufacturers highlight interchangeable cartridge systems that let facilities retrofit existing fittings with metering or ceramic‑gear components,...

NeenOpal Achieves the AWS AI Competency in Generative AI and Agentic AI Categories
NeenOpal announced it has earned the Amazon Web Services (AWS) AI Competency in both the Generative AI and Agentic AI categories. The designation confirms the firm’s technical depth and its track record of turning experimental AI pilots into production‑ready solutions...

Government ‘Information Gateway’ Will Share Public-Held Data with Digital Verification Services
The UK Office for Digital Identities and Attributes has introduced an "information gateway" that permits private sector verification providers to access public‑held identity data. The capability is authorised by Section 45 of the Data Use and Access Act 2025 and...

AI Tech Collab Takes on SA’s Energy Distribution Crisis
South African energy tech firm Plentify and developer Balwin Properties have launched an AI‑driven geyser management system using HotBot devices to optimise residential water heating. The controllers, now deployed in over 7,500 homes, adjust heating based on occupancy patterns, solar...

New AI Policy in South Africa Stresses Corporate Liability for Agentic Systems
South Africa’s new AI policy treats autonomous, or “agentic,” systems as delegated decision‑makers and places full corporate liability on the deploying organisation. The Companies Act 71 of 2008 and the Electronic Communications and Transactions Act 25 of 2002 require board‑level...

Can AI Read Your Homepage?
Adobe reports AI chat platforms drove a 269% year‑over‑year surge in referral traffic to U.S. retail sites in March 2026, with overall AI‑generated traffic up 393% for Q1. Its AI Content Visibility Checker found that 75% of retailer homepages are...

Orchestrate ABM Around Main Characters, Not Extras: Lessons From B2BMX
At B2B Marketing Exchange 2026, LiveRamp’s Ed Vander Bush and Influ2’s Doug Madey urged marketers to treat individual decision‑makers and hidden stakeholders as the main characters of ABM, not the entire account. They argued that synchronizing marketing and sales around real‑time...

I Gave Edge on Android a Real Chance and It Solved My Biggest Problem with Chrome
Microsoft Edge on Android has introduced beta support for browser extensions, a feature long missing from Google Chrome’s mobile version. The addition lets users install tools such as Dark Reader, Bitwarden, and Keepa, bringing desktop‑level functionality to phones. Combined with...

When AI Talks Nonsense: Why It’s Not the End of the Story
Many users dismiss AI after receiving inaccurate or nonsensical answers, but the issue often lies in how they communicate with the model. The article argues that adopting a conversational, humble tone and iteratively refining prompts can dramatically improve response quality....

New Tech Tool Aims to Help Employees Navigate Leave Benefits
Alight introduced the Leave Planner, a digital, AI‑driven tool that simplifies short‑term and long‑term leave administration for employees. The platform lets users input expected dates, see projected pay and benefit impacts, and automatically populates required data from existing records. By...

AI in the Interview Room
Technical interviews are increasingly skewed by AI‑assisted preparation, producing candidates who appear highly competent but may lack depth once on the job. As talent shortages intensify, recruiters face a flood of polished resumes and interview responses that mask real capability....

The Identity Crisis Coming for News SEO
Google is experimenting with AI‑generated headlines and summaries that rewrite or replace news publishers' original titles, as seen in a recent test on The Verge. The move extends to Google Discover, which now auto‑summarizes headlines, sometimes producing inaccurate or misleading...

The Digital Accessibility Deadline Is Here. Schools Aren’t Ready.
The federal Title II ADA rule requiring K‑12 schools and districts to meet WCAG 2.1 Level AA standards takes effect on April 24, 2026, with smaller districts facing a 2026 deadline and larger ones 2027. A recent NSPRA survey shows only 14% of districts have...

This Beanie Is Designed to Read Your Thoughts
California startup Sabi has emerged from stealth with a brain‑reading beanie that translates imagined speech into text. The wearable relies on an ultra‑dense EEG array of 70,000‑100,000 sensors and a brain‑foundation AI model trained on 100,000 hours of data from...

The World’s Largest Ad Holding Company Just Bet Its AI Future on One Vendor
Publicis Groupe has deepened its partnership with Microsoft, creating a full‑stack agentic marketing platform that combines Azure cloud, Copilot tools, and Publicis’ Epsilon data and Sapient consultancy. The deal makes Azure the preferred cloud for Publicis and rolls out Microsoft...

Finance Regulators to Address AI Risks After MPs Say They Are ‘Not Doing Enough’
UK regulators are stepping up AI oversight after a Treasury Committee report accused them of inaction. The Bank of England announced trials of AI agents in trading markets to study herding effects, while the FCA said it will issue best‑practice...

InfraXmedia Launches AI Cities Summit Series to Support Governments Navigating AI Infrastructure Growth
InfraXmedia has launched the AI Cities Summit Series, a global platform that helps national, regional and city governments plan, attract and scale AI infrastructure. The inaugural European edition will be held in Zaragoza on February 16‑17, 2027, backed by the...

UK Set to Launch £500m ‘Sovereign AI’ Fund
The UK government is unveiling a £500 million (≈$635 million) Sovereign AI fund, designed to act as an internal venture capital vehicle, provide access to AI supercomputers, and facilitate procurement and regulatory guidance for domestic AI firms. Technology Secretary Liz Kendall framed...

PV Module Prices Continue to Rise Unabated
Photovoltaic module prices climbed for the fourth month in a row, rising 5.5% between March and April 2026, with all‑black modules posting the steepest gains. The increase occurs despite falling polysilicon costs and the removal of Chinese export tax credits,...

Freshworks to Host Webinar on Tackling IT Complexity in the Age of AI
Freshworks, in partnership with YourStory, is hosting a live webinar on April 24, 2026, to address the growing challenge of IT complexity in the era of AI. The session will feature Freshworks product and solution leaders discussing practical strategies for...

UniverCell Canada Expands Through Franchising Growth
UniverCell Canada, a bootstrapped electronics repair retailer, opened a new store in Mississauga, bringing its footprint to 17 locations across Ontario, Manitoba and Quebec. The company’s growth is driven by a franchise model that allows rapid expansion without heavy corporate...

What Happens When You Stop Ozempic or Mounjaro? New Study Reveals Surprising Weight-Loss Results
A Cleveland Clinic analysis of nearly 8,000 Ohio and Florida adults who stopped GLP‑1 injectables—semaglutide (Ozempic/Wegovy) or tirzepatide (Mounjaro/Zepbound)—found minimal weight regain. Patients treated for obesity lost an average of 8.4% of body weight and regained only 0.5% after one...

Revealing the Intrinsic Electronic Structure of 2D MoS2 Buried Beneath Thick Dielectric Overlayer via Hard X‐ray Photoelectron Spectroscopy
Researchers applied hard X‑ray photoelectron spectroscopy (HAXPES) to molybdenum disulfide (MoS2) capped with a 20‑nm AlOx dielectric, mimicking real‑device heterostructures. Using a Cr‑Kα source, HAXPES achieved more than twice the information depth of conventional Al‑Kα XPS, allowing access to deeper...

Unlocking Wind Turbine Longevity with Smarter Lubrication
The wind power market is set to reach 3,207 GW of installed capacity by 2035, driving demand for more reliable turbine operation. Effective lubrication is critical, as drivetrain failures can quickly halt production, especially in offshore and remote sites. Mobil introduced...

Decoding Agnikul’s Cosmos Race With SpaceX On 3D-Printed Rocket Engine
Agnikul Cosmos, an IIT Madras‑incubated startup, has demonstrated the Agnite engine – the world’s largest single‑piece 3D‑printed semi‑cryogenic rocket engine – in a successful test‑fire. The engine’s 3‑month‑to‑week manufacturing cycle and reusability aim to lower launch costs for sub‑tonne payloads,...

FCA Targets AI Governance and Off-Channel Messaging
In February 2026 the FCA replaced a backlog of individual letters with a series of sector‑specific Regulatory Priorities reports, beginning with insurance and followed by wholesale markets, retail banking and consumer investments. The reports signal a collaborative stance on artificial...

Highly Efficient Hydrogen Peroxide Production Over S‐Scheme G‐C3N4/COF Heterojunction Through Dual‐Channel Photocatalysis
Researchers have developed a plasma‑assisted S‑scheme heterojunction of graphitic carbon nitride (g‑C3N4) and a triazine‑based covalent organic framework (COF) that photocatalytically generates hydrogen peroxide under visible light. The dual‑channel design simultaneously drives oxygen reduction and water oxidation, delivering a production...

Capture, Confine, Characterize: High‐Throughput Dielectrophoresis‐Based Single‐Cell Microfluidics Platform to Analyze Mammalian and Yeast Cells Using Raman Spectroscopy
Researchers unveiled the Microfluidic Dielectrophoretic Arresting System (MiDAS), a compact microelectrofluidic platform that uses dielectrophoresis to trap single mammalian cells, yeast, beads, and water‑in‑oil droplets at high throughput. The device features interchangeable trap geometries—20 µm for cells and beads, 40 µm for...

Aixtron’s Preliminary Q1 Order Intake up 30% Year-on-Year, Driven by Opto Comprising 65% Share
German deposition equipment maker Aixtron reported preliminary Q1 2026 revenue of about €59 m (~$71 m), a 48% decline from a year earlier, while gross margin fell to roughly 18%. Despite the revenue drop, order intake jumped 30% YoY to €171 m (~$205 m),...

AI Bots - a New Risk and Opportunity for CIOs to Manage
AI‑generated bots are flooding corporate web estates, with Akamai reporting a 300% rise in AI‑driven traffic and some CIOs seeing a 400% jump in site crawls. The surge inflates API, cloud and CDN usage, driving up operating expenses and degrading...

AI and Executive Protection: New Risks, New Defenses
AI‑generated phishing attacks are now targeting corporate executives with hyper‑personalized emails crafted from public profiles and generative AI. The barrier to launch such campaigns has collapsed, allowing amateurs to produce convincing phishing kits and doxing databases. Security teams can counter...

AI Takes Centre Stage at SBC Summit Malta 2026 Through Hands-On Workshops
SBC Summit Malta 2026 will feature AI‑focused workshops that give gaming operators, developers and regulators hands‑on experience with machine‑learning tools. The sessions showcase practical applications such as fraud detection, player personalization and operational automation. Organizers stress that the industry is...

Revisiting the Photoelectric Conversion Mechanism in Hydrothermally Deposited Sb2(S,Se)3 Solar Cells
Researchers have uncovered a new photoelectric conversion mechanism in hydrothermally deposited Sb2(S,Se)3 solar cells. Annealing drives selenium into the CdS buffer, forming a gradient‑bandgap Cd(S,Se) layer that, together with Sb2(S,Se)3, creates a V‑shaped mixed absorber. This structure separates electron‑hole pairs...

Could AI’s Leading Men Become as Powerful as Ford or Rockefeller?
The article likens today’s AI titans—Sam Altman, Dario Amodei, Demis Hassabis, Elon Musk and Mark Zuckerberg—to historic industrial magnates like Henry Ford and John D. Rockefeller. It highlights their outsized public profiles, massive user bases such as ChatGPT’s 900 million weekly users,...
Programmable Targeted Hypermutagenesis via Diversity-Generating Retroelements
Researchers unveiled DGRec, a Diversity‑Generating Retroelements‑recombineering platform that delivers programmable, targeted hypermutagenesis in *E. coli*. The system harnesses DGR reverse transcriptase bias to achieve mutation rates of up to 1.38 × 10⁻² per base, generating up to 24 mutations within 48 hours across...

STAT+: Roche to Launch Another Elevidys Trial, with Eyes on European Approval
Roche announced a new Phase 3 trial of Elevidys, the gene‑therapy for Duchenne muscular dystrophy, targeting European approval after a negative EMA review last year. The study will enroll roughly 100 boys in the early stages of the disease and compare...

Cape Town’s First MyCiTi E-Bus to Arrive in August
Cape Town will receive its first MyCiTi electric bus in August, followed by 13 more before year‑end, as part of a rollout of 30 Volvo BZRLE low‑floor e‑buses slated for delivery through June 2027. The buses feature bodies manufactured locally in...

Surface Modulation, Optics, and Electrochemical Hydrogen Evolution Studies on CdS‐Ag2S Superlattice Heterostructures
Researchers synthesized CdS‑Ag2S superlattice heterostructures using two ligand‑mediated routes, producing random ODA‑capped quantum‑dot assemblies and ordered DDT‑capped nanorod arrays. Electron microscopy and X‑ray spectroscopy confirmed distinct domain ordering, which altered charge carrier recombination lifetimes. The ordered DDT‑capped superlattices displayed faster...

LEO Pharma Reports the US FDA’s sNDA Acceptance of Anzupgo for Use in Children with Chronic Hand Eczema
LEO Pharma announced that the U.S. Food and Drug Administration has accepted a supplemental New Drug Application for Anzupgo (delgocitinib) cream targeting adolescents aged 12 to 17 with moderate‑to‑severe chronic hand eczema. The acceptance follows the Phase III DELTA TEEN trial, which...